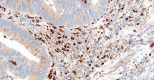

Role of macrophages in progression of colorectal cancer: a contrast with the traditional paradigm
- PMID: 36381422
- PMCID: PMC9638838
Role of macrophages in progression of colorectal cancer: a contrast with the traditional paradigm
Abstract
The phenotype of tumor-associated macrophages may be critical for tumor immunity, angiogenesis, and clinical disease outcome. Here, we elucidated the prognostic significance of the neovasculature and macrophages in colorectal cancer. We analyzed the effect of M2 macrophage density on the clinical behavior of 151 primary colorectal carcinomas using CD206 as a marker for type 2 macrophages. Triple immunohistochemical staining (ERG, SMA, and podoplanin) was used for microvessel evaluation. We found that M2 macrophages in colorectal cancer did not have a direct association with metastatic behavior. However, high numbers of CD206 tumor-associated macrophages correlated positively with recurrence-free interval duration (P=0.005). Fewer macrophages in the tumor microenvironment resulted in insufficient coverage of newly formed vessels by pericytes (P=0.011), and a high number of pericyte-impaired microvessels correlated with metastatic behavior (P<0.001). These results suggested that type 2 macrophages had a role in limiting the metastatic process by affecting vascular maturity and normalization. These findings contribute to understanding complex interactions in the tumor microenvironment and the clinical behavior of colorectal cancer.
Keywords: Colorectal cancer; M2; alternatively activated macrophages; angiogenesis; prognosis; tumor microenvironment.
IJCEP Copyright © 2022.
Conflict of interest statement
None.
Figures

References
-
- Mills CD, Kincaid K, Alt JM, Heilman MJ, Hill AM. M-1/M-2 macrophages and the Th1/Th2 paradigm. J Immunol. 2000;164:6166–6173. - PubMed
LinkOut - more resources
Full Text Sources
